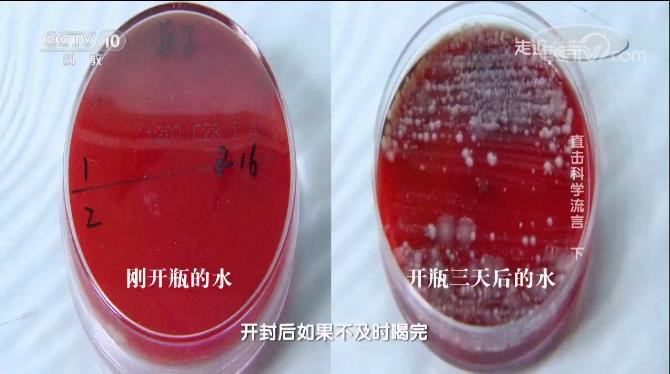
亚硝酸盐|千滚水、隔夜水和电壶水，有毒且致癌？央视的一个实验告诉你真相

文章图片

文章图片
文章图片

文章图片
根据生物学家报告 , 水占据了人体体重的六七成 , 人是“水”做的 , 维持生命离不开水 。 但是就喝水这件事来说 , 谣言却也层出不穷 。
有传言称 , 用电壶水反复烧开的水 , 或者白开水放置隔夜 , 会产生过量的亚硝酸盐 , 人体服用之后 , 会引起中毒、致癌 。 事实果真如此吗?
?一、千滚水、隔夜水、电壶水 , 会增加亚硝酸含量吗?
针对于此 , 央视栏目组《走进科学》和广东省食品检验所一起进行了相关实验 。
实验室人员分别选择了纯净水、自来水 , 并各自选取三个样本 , 方便进行平行对比以及加样 。
第一次取样 , 实验人员用电水壶对纯净水以及自来水反复烧开2小时后 , 冷却取样;第二次取样反复烧开4小时 , 冷却取样 , 最后一次则是将水煮沸隔夜后取样 。
?实验室通过检测设备进行亚硝酸盐测量 , 结果发现 , 没有反复煮过、没有放置之后的情况下 , 亚硝酸含量是没有增加的 。 经过多次煮沸的水和放置隔夜的水 , 亚硝酸盐含量确实有所增加 。
为了进一步验证 , 实验室又采取了离子色谱对水样进行检测 , 结果仍然证明 , 反复煮沸的水 , 无论是纯净水还是自来水 , 亚硝酸盐含量均有增加 , 只是前者会比后者的含量相对较低 。
?二、那千滚水、隔夜水、电壶水 , 还能喝吗?
隔夜水、千滚水确实存在亚硝酸盐 , 那是否意味着传言的观点是正确的呢?
对此 , 广东省食品检验所雷毅副所长表示 , 虽然饮用水中亚硝酸盐有所增加 , 但多次煮沸的水 , 亚硝酸盐含量极低 。
即便是反复煮沸18次 , 放置了24小时 , 纯净水中的亚硝酸盐也只是达到了限量的0.5% , 自来水则达到了1% , 但都远远低于我国生活饮用水国际规定的限量 , 生活饮用水卫生标准GB5749-2006限量为1mg/L 。
因此 , 喝隔夜水、千滚水并不会造成亚硝酸盐中毒、致癌 。
?但是隔夜水和千滚水 , 还是不建议喝 , 因为放置过久的水 , 细菌超标、微生物含量增加的可能性增加 , 从食品安全角度考虑 , 并不建议再饮用 。
将瓶装水放置3天之后 , 检测到其中的微生物含量已经是明显超标 。 煮沸之后的水在放置后也有微生物增长的情况 , 所以还是尽量喝新鲜的水 。
?事实上 , 亚硝酸盐中毒 , 主要是因人体一次性摄入大量的亚硝酸盐 , 亚硝酸盐会让血红蛋白无法正常运输氧气 , 使人体神经由于缺氧 , 引起的急性中毒 。
而亚硝酸盐本身不具有致癌性 , 而是进入到人体后 , 与仲胺、叔胺及氨基酸反应 , 结合生成强致癌物亚硝胺 , 这是亚硝酸盐的慢性中毒 。
?根据国家《生活饮用水卫生标准》规定 , 饮用水中的亚硝酸盐含量每升不得超过1毫克 , 而世界卫生组织规定 , 人体亚硝酸盐的日摄入量为0—0.2毫克每公斤 。 也就是相当于 , 小明70公斤 , 每天摄入不超过14毫克的亚硝酸盐 , 都在身体承受范围 。
人体要达到中毒程度 , 剂量约为0.3—0.5克 , 致死量则为3克左右 , 因此并不会对健康造成威胁噢 。
- |吸烟的人,谨记这两个时间千万别抽,可能比吸一包烟的危害还大
- 湖南女孩刘静“千杯不醉”,喝倒七八个壮汉,医院检查发现问题
- 长寿|中国人喝粥能否长寿?两千年的秘密,却被外国人给揭开了
- 甲亢|夏季当心甲亢“突袭”,出现这些信号千万别大意
- 千万不要这么走
- 在希望的田野上 | 山西高平千亩辣椒喜丰收 拓宽村民致富路
- 在希望的田野上 | 千亩梯田蜿蜒层叠 广袤土地绘就勃勃生机
- 「下基层察民情解民忧暖民心」襄城区千亩堰水产养殖合作社:让旧产业焕发新生机
- 「下基层 察民情 解民忧 暖民心」襄城区千亩堰水产养殖合作社:让旧产业焕发新生机
- “头孢送酒,一喝就走”是谣言?提醒:吃这5类药物,千万别喝酒
